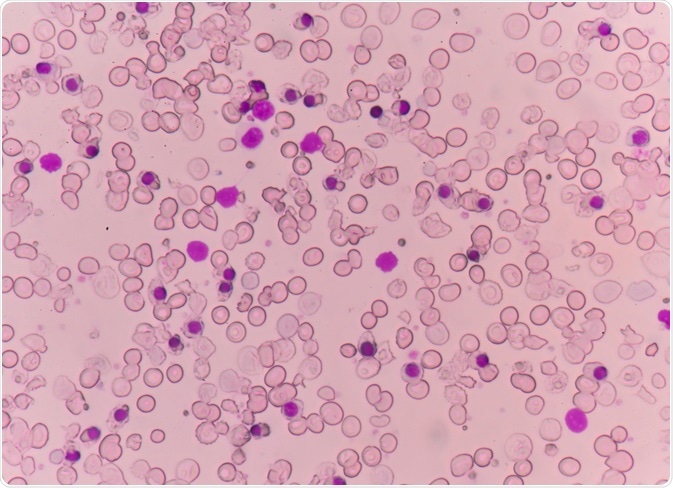
thalassemia

The treatment for thalassemia can vary greatly according to the individual circumstances and the presenting symptoms. Some patients may carry a gene mutation but not experience any symptoms, also known as a silent carrier, who will not usually need any treatment. On the other hand, patients may experience significant symptoms and be reliant on regular medication.
Individuals with a single gene mutation affecting the beta part of the hemoglobin or a double mutation affecting that alpha part usually have mild symptoms of thalassemia, known as thalassemia intermedia. If more gene mutations are present, the severity of the symptoms generally increases.
Depending on the individual case and presenting symptoms, treatment may not be needed and should be sought on an as-required basis. For patients with moderate or severe types of thalassemia, blood transfusions are often necessary on a frequent basis.
Abnormal red blood cells in a thalassemia patient's blood smear. Image Credit: Schira / Shutterstock.com
Abnormal red blood cells in a thalassemia patient's blood smear. Image Credit: Schira / Shutterstock.com
Lifestyle modifications
Initially, particularly for mild cases of thalassemia, individuals should make small modifications to their diet and lifestyle to help in the management of the condition.
It is important to eat a balanced diet with fresh nutritious foods, as this can help patients to feel more energized. In some instances, supplementation of folic acid may be recommended to encourage red blood cell growth and calcium and vitamin D for added bone strength.
Due to the increased risk of individuals with thalassemia experiencing an overload of iron, it is recommended to avoid excess iron. For this reason, vitamins or supplements that contain iron should usually be avoided.
Additionally, taking measures to reduce the risk of infections can be beneficial. This includes washing hands frequently and avoiding contact with people that are sick. Immunizations to protect from influenza, meningitis, pneumococcal disease and hepatitis B are also recommended.
Blood transfusion
Some patients will require a blood transfusion on a regular basis or in particular circumstances, such as after surgery, delivering a baby or experiencing complications of the condition.
This treatment supplies the body with red blood cells and normal hemoglobin. An intravenous infusion is administered over a period of 1-4 hours and the red blood cells circulate in the body for up to 120 days. For this reason, a subsequent transfusion is usually required a few months later, or 2-4 weeks for particularly severe cases such as thalassemia major.
A common side effect of regular blood transfusions is a build-up of iron leading to overload. For this reason, many patients that require blood transfusions consequently need iron chelation therapy.
 Comparison between normal blood and thalassemia. Image Credit: Ody_Stocker / Shutterstock.com
Comparison between normal blood and thalassemia. Image Credit: Ody_Stocker / Shutterstock.com
Iron chelation
Overload of iron is a common issue for people with thalassemia and many patients require treatment to manage this, as it can damage the heart, liver and other organs. Overload can occur as a consequence of blood transfusions, or due to the increased absorption of iron from the digestive tract associated with this condition.
To manage iron overload, an oral medication such as deferasirox (Exjade) or deferoxamine is indicated. These can help to lower the load of iron, thus offering a level of protection for the important organs that may be affected.
Stem cell transplant
For severe cases of thalassemia, a stem cell or bone marrow transplant may offer a benefit. This is reserved as a last-line therapy, however, as the side effects can be serious and, in some cases, fatal.
The treatment involves high doses of drugs or radiation therapy in the initial stages to remove diseased cells from the bone marrow. Following this, stem cell infusions are administered from a donor with compatible cells, such as a sibling or close family member, to promote the growth of healthy cells.
What is Thalassemia? Types, Treatment and Symptoms
References
Further Reading
Last Updated: Feb 23, 2021